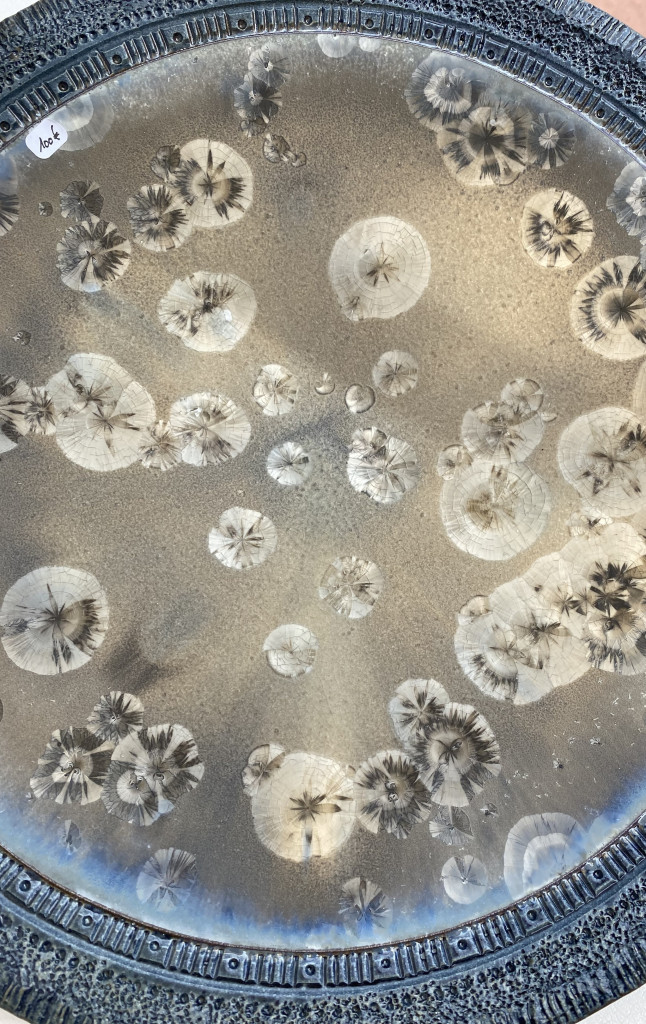

Impressionen
Impressionen vom
Töpfermarkt Freudenstadt
2025

Der Obere Marktplatz von Freudenstadt.
Blick von oben auf einen Teil des Töpfermarktes.

Keramik ist vielseitig in der Gestaltung und hat sowohl
praktische wie auch dekorative Seiten.

Bunte Fayancen mit Platinveredelung.
Farbgehaucht in federleichter Ausführung.


Geschirr in unterschiedlichster Ausführung.



Keramik ist vielmehr als nur Geschirr.
Figurative Keramik und andere künstlerisch gestaltete
Keramik gehört selbstverständlich auch zum
Töpfermarkt.

Marktszene mitten in Freudenstadt

Echsen in Gold
oder
Plastiken in ganz archaischer Ausführung ...
.... Keramik hat viele Seiten

Schwarzweiße Keramik ist Kontrast pur wie diese Teller
im Bild unten. Eine weitere Seite der Keramik.

Steinzeuggeschirr ist sehr robust und bietet
viele Gestaltungsmöglichkeiten
Diese Blumen verwelken nicht

Diese Lichtkugel ist sowohl für Drinnen wie auch
Draußen geeignet.

Handgemachte Fliesen - so macht Architektur Spaß!

Besondere Einzelstücke, hier eine Schale mit einer
außergewöhnlichen Kristallglasur, sind ein echter
Hingucker.....
... oder wie die Figuren unten.

Rakukeramik bietet immer wieder Überraschungen.
Die besondere Brenntechnik macht es möglich.

Auch Schmuck aus Keramik ist möglich wie dieses
schöne Beispiel aufzeigt.
.... und noch vieles mehr an individueller Keramik
gibt es auf dem Töpfermarkt in Freudenstadt.
Handgetöpferte Keramik -
Vielfalt mit der ganz persönlichen
Note. Gehen Sie auf Entdeckertour.
Der Töpfermarkt Freudenstadt
lädt Sie dazu ein.
Der Töpfermarkt in Freudenstadt
Der Marktplatz von Freudenstadt gilt als der größte Marktplatz in Deutschland.
Berühmt ist er aber nicht nur aufgrund seiner Größe, sondern wegen seiner Bebauung. Die Gebäude besitzen alle im Erdgeschoss Arkaden, was den Gebäuden eine gewisse Leichtigkeit vermittelt. Ein schöner Rahmen für den Töpfermarkt mitten im nördlichen Schwarzwald.
Keramik -
handgemacht und kreativ
Handgemachte Keramik ist Vielfalt pur.
Der Grundstoff "Ton" bietet unglaublich viele Möglichkeiten, kreativ damit zu werken.
Der Geist und die Hände sind das Werkzeug.
Der Drang des schöpferischen Handelns steckt wohl tief in uns drin, denn seit der Jungsteinzeit wussten die Menschen damit umzugehen.
Die unmitttelbare Erfahrung, was die Finger erspüren, animiert wohl schon immer unser Dasein.
So entwickelten sich so viele Spielarten an Keramik - und das weltweit und einzigartig.
Egal ob für den täglichen Gebrauch als Geschirr,
ob als Mauer- und Dachziegel,
als Wand- und Bodenverkleidung,
als Ofenkacheln,
als Ritualgefäße,
als künstlerische Einzelstücke,
als archtektonisches Bildzeichen.
Keramik ist schon immer ein beliebter Werkstoff für die Gestaltung unserer Umwelt.
Stilarten
Spielarten
Jeder Topf findet seinen Deckel, dieses Sprichwort passt für viele Lebensbereiche (nicht nur bei der Partnersuche).
Und wo findet man mehr Spaß bei der Suche nach einem "Deckel" als bei einem Töpfermarkt.
Auf dem Töpfermarkt Freudenstadt ist eine große Vielfalt an Keramik vertreten.
Was kann Mann und Frau da nicht alles an individueller Keramik entdecken:
ob verspielt oder puritanisch,
ob Mix oder klare Linie,
ob tierisch oder grafisch,
ob skuril und seltsam,
ob bunt oder monochrom,
ob für den täglichen Gebrauch oder als Dekoration,
ob für den Garten oder das Wohnzimmer (oder Schlafzimmer, Bad oder wie auch immer),
ob zum Verschenken oder zum selbst behalten,
ob ein besonderes künstlerisches Einzelstück oder als schöne Keramik für den Tisch ...
...
viele Stil- und Spielarten
sind auf dem
Töpfermarkt Freudenstadt
vertreten.
Das Schöne ist, dass Keramik sehr beständig ist und durch die Handarbeit eine besondere Ausstrahlung hat.
Da stehen Menschen dahinter, die sich der Keramik verschrieben haben. Das macht sie so sympathisch.
Diese Vielfalt an Keramik macht diesen Markt so einzigartig.
Finden auch Sie Ihren "Deckel".
Diese Auswahl an Bildern zeigt die Vielfalt an Keramik, die auf dem Töpfermarkt Freudenstadt präsentiert wird.
Gehen Sie auf Entdeckungstour. Lassen Sie sich überraschen von den schönen Keramikarbeiten, die die Töpferinnen, Künstler und Keramiker auf dem Marktplatz in Freudenstadt Ihnen in Ihren Verkaufsständen anbieten.
Keramik ist Leidenschaft
in vielen Facetten
Über
Ihren
Besuch
auf dem
Töpfermarkt
in Freudenstadt
freuen wir uns!
Ihre
Töpferinnen
und Töpfer,
Keramiker und
Künstler
